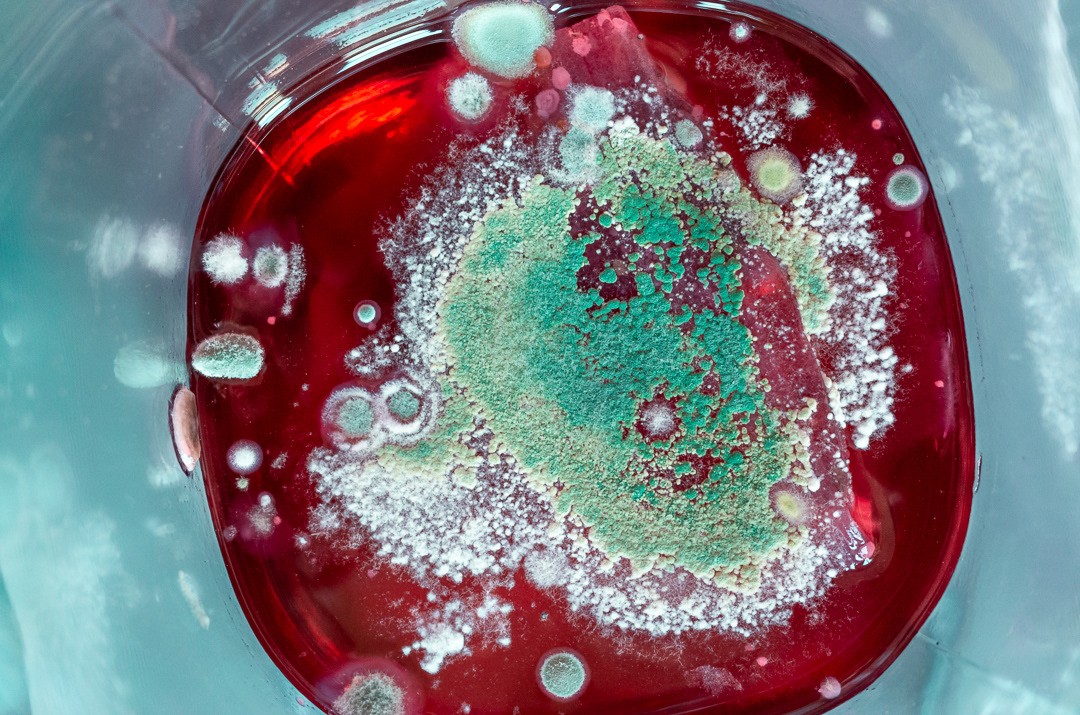

Curators, publishers, and anyone interested in exploring this series further are invited to read the full Artist Statement.


















































Stills is a fine art photography series reflecting on stillness, presence, and everyday rituals, inviting a slower way of seeing and appreciating what already exists.